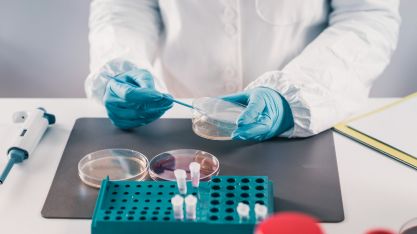
Microbiologiste travaillant dans un laboratoire

Les sessions de formation d’Intertek Academy vous aideront à comprendre, à mettre en œuvre et à améliorer vos pratiques et processus d’entreprise afin de garantir une amélioration continue du système de gestion de votre organisation ou de mieux appréhender d’un point de vue Qualité et Sécurité la conception de vos produits.
Notre réseau d’auditeurs et de formateurs possède une vaste expérience de l’assurance qualité totale afin de vous offrir les conditions idéales pour augmenter votre rentabilité, renforcer votre marque et être plus compétitif.
- Formation sur mesure : en entreprise adaptés aux besoins spécifiques des clients
- Formation E-Learning : modules et parcours adaptés à vos besoins et vos métiers
- Formation inter-entreprise : programmes variés de formations spécialisées
Découvrez ci-dessous les différents secteurs d'activités de nos cours :